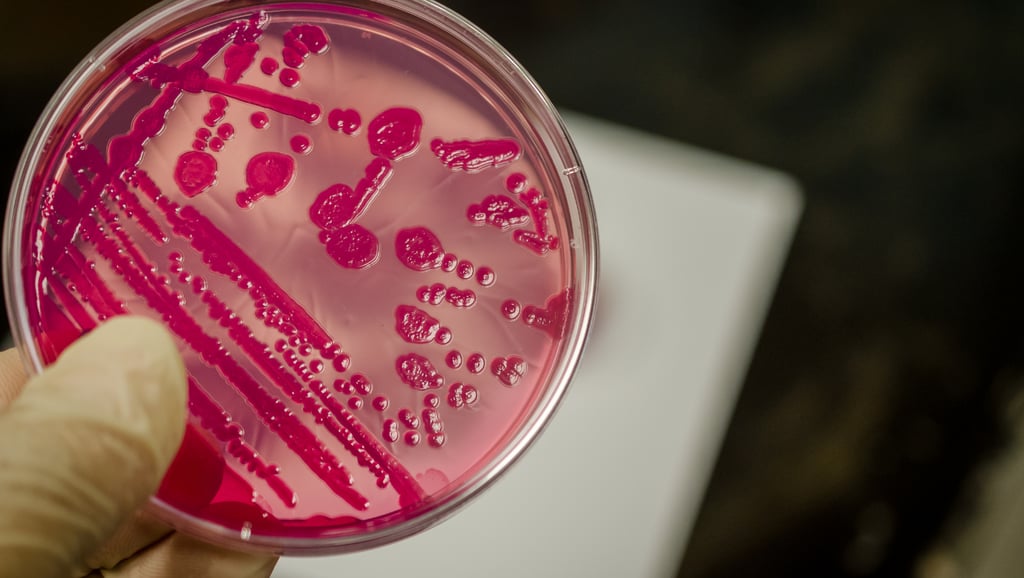
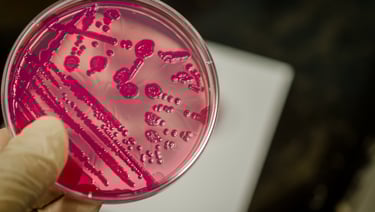

Salmonela e Shigella: Diferenças, Sintomas e Como Prevenir Infecções Bacterianas
Entenda como essas bactérias atuam no organismo e quais medidas tomar para evitar contaminações
05/02/2025
5 min ler

O que são Salmonela e Shigella?
As bactérias Salmonela e Shigella pertencem a grupos distintos, sendo ambas relevantes na microbiologia e na saúde pública devido ao seu papel na causação de doenças gastrointestinais. A Salmonela é um gênero de bactérias gram-negativas que inclui várias espécies, sendo a mais comum a Salmonella enterica, responsável por grande parte das infecções alimentares. Ela se divide em subespécies, com diversas sorotipos, como a Salmonella Typhimurium e a Salmonella Enteritidis, que são frequentemente associados a surtos alimentares.
Por outro lado, a Shigella é um gênero que abrange quatro espécies principais: Shigella dysenteriae, Shigella flexneri, Shigella boydii e Shigella sonnei. Essas bactérias são conhecidas por provocar a shigelose, uma infecção intestinal que traz sintomas como diarreia e febre, muitas vezes acompanhada de muco ou sangue nas fezes. As diferentes espécies de Shigella variam em virulência e em seu impacto sobre a saúde pública.
Ambas as bactérias prosperam em ambientes com condições inadequadas de saneamento e higiene, favorecidas por alimentos ou água contaminados. A Salmonela geralmente se associa a produtos de origem animal, como carnes, ovos e laticínios, enquanto a Shigella está mais relacionada à transmissão fecal-oral, sendo comum em áreas com altas taxas de multidão e baixa higiene. Estruturalmente, Salmonela e Shigella diferem em sua capacidade de invadir células hospedeiras e em seus mecanismos de patogenicidade, refletindo suas adaptações evolutivas a diferentes ambientes.
Sintomas de infecção por Salmonela e Shigella
As infecções causadas pelas bactérias Salmonela e Shigella manifestam sintomas que podem ser muito semelhantes, dificultando o diagnóstico sem uma avaliação clínica adequada. Ambas as infecções geralmente se apresentam com diarreia, dor abdominal, febre e vômitos, mas existem nuances importantes a serem consideradas.
No caso da infecção por Salmonela, os sintomas podem surgir entre 6 a 72 horas após a exposição ao patógeno. Tipicamente, a diarreia associada à Salmonela é mais intensa e pode ser acompanhada por cólicas abdominais significativas. Pacientes costumam relatar febre moderada, que pode alcançar até 39°C, e episódios de vômito, embora estes não sejam sempre presentes. A duração dos sintomas pode variar, mas geralmente se resolve em 4 a 7 dias, embora algumas pessoas possam experimentar um quadro prolongado.
Por outro lado, a infecção por Shigella tende a provocar sintomas mais graves que surgem rapidamente, geralmente entre 1 a 3 dias após a ingestão de alimentos ou água contaminados. A diarreia é frequentemente acompanhada de sangue e muco, o que pode ser um sinal distintivo desta infecção. As dores abdominais são intensas, e a febre pode ser alta, chegando a 40°C. A doença pode ser debilitante, levando à desidratação, especialmente em crianças e idosos. O quadro clínico costuma durar de 5 a 7 dias, mas, em casos mais severos, pode se estender além desse período.
Entender os sintomas de infecções por Salmonela e Shigella é crucial para um diagnóstico correto e um tratamento eficaz. As diferenças nos padrões de sintomas e sua gravidade podem ajudar profissionais de saúde a tomar decisões apropriadas, considerando ou não a necessidade de intervenções mais complexas, como a hidratação intravenosa ou o uso de antibióticos.
Diferenças entre Salmonela e Shigella
A Salmonela e a Shigella são ambas bactérias patogênicas que causam infecções gastrointestinais, mas apresentam características distintas em seus mecanismos de infecção e transmissão. A Salmonela é frequentemente associada ao consumo de alimentos contaminados, especialmente carnes cruas ou mal cozidas, ovos e produtos lácteos. Por outro lado, a Shigella é predominantemente transmitida através da rota fecal-oral, sendo mais comum em ambientes com higiene precária, como em comunidades superlotadas ou durante surtos em creches.
Do ponto de vista epidemiológico, a Salmonela possui diversas sorovariedades, com algumas, como a Salmonela enteritidis e a Salmonela typhimurium, sendo responsáveis por infecções mais comuns. As infecções por Salmonela podem resultar em sintomas que vão da diarreia à febre alta e cólicas abdominais, geralmente autolimitadas, embora possam levar a complicações graves, especialmente em indivíduos imunocomprometidos. Em contraste, a infecção por Shigella é frequentemente mais grave e pode provocar diarreia sanguinolenta, febre e dor abdominal intensa. A Shigella dysenteriae, em particular, pode causar surtos significativos, ainda mais preocupantes devido à sua baixa dose infecciosa, o que significa que até uma pequena quantidade de bactérias pode causar doença.
Além disso, a suscetibilidade populacional difere entre as duas bactérias. Crianças, idosos e pessoas com sistemas imunológicos comprometidos estão em maior risco de desenvolver complicações severas em ambos os casos. Entretanto, enquanto a Salmonela afeta uma ampla gama de grupos etários, a Shigella tende a afetar mais fortemente as crianças, especialmente em situações de surtos epidêmicos. Em termos de saúde pública, o controle de infecções por Salmonela é muitas vezes focado na segurança alimentar, enquanto a prevenção de surtos de Shigella envolve a melhoria das condições de saneamento e higiene.
Como prevenir infecções por Salmonela e Shigella
A prevenção de infecções por Salmonela e Shigella requer uma combinação de cuidados na manipulação de alimentos e práticas adequadas de higiene pessoal. O primeiro passo importante é garantir a segurança alimentar. Ao manusear alimentos, é essencial lavar bem as mãos com água e sabão antes e depois do preparo. Além disso, utensílios e superfícies que entram em contato com carnes cruas, ovos ou produtos lácteos devem ser desinfetados adequadamente, reduzindo assim o risco de contaminação cruzada.
Outro aspecto fundamental é o controle das temperaturas de cozimento dos alimentos. Os alimentos devem ser cozidos completamente, especialmente carnes e ovos, que necessitam atingir temperaturas internas adequadas para eliminar potenciais patógenos. Além disso, é recomendável evitar o consumo de produtos crus ou mal cozidos, como ovos crus e carnes processadas, que podem estar associados a surtos de Salmonela e Shigella.
A higiene pessoal eficiente é igualmente crucial. Banhos frequentes e a utilização de desinfetantes para as mãos são recomendados, especialmente em situações em que a lavagem com água e sabão não é possível. Isso é particularmente importante em ambientes públicos, onde a probabilidade de exposição a essas bactérias aumenta. A educação sobre a importância das boas práticas de higiene em escolas e locais de trabalho tem um papel significativo na prevenção de infecções.
Por fim, é vital que as pessoas estejam conscientes sobre o que fazer ao apresentar sintomas graves, como diarreia severa ou sangramento. Nestes casos, buscar atendimento médico rapidamente pode ser determinante para o tratamento eficaz e para a prevenção da propagação da infecção. A conscientização e a educação contínua, tanto em ambientes domésticos quanto comerciais, são essenciais para reduzir a incidência de infecções por Salmonela e Shigella na população.

